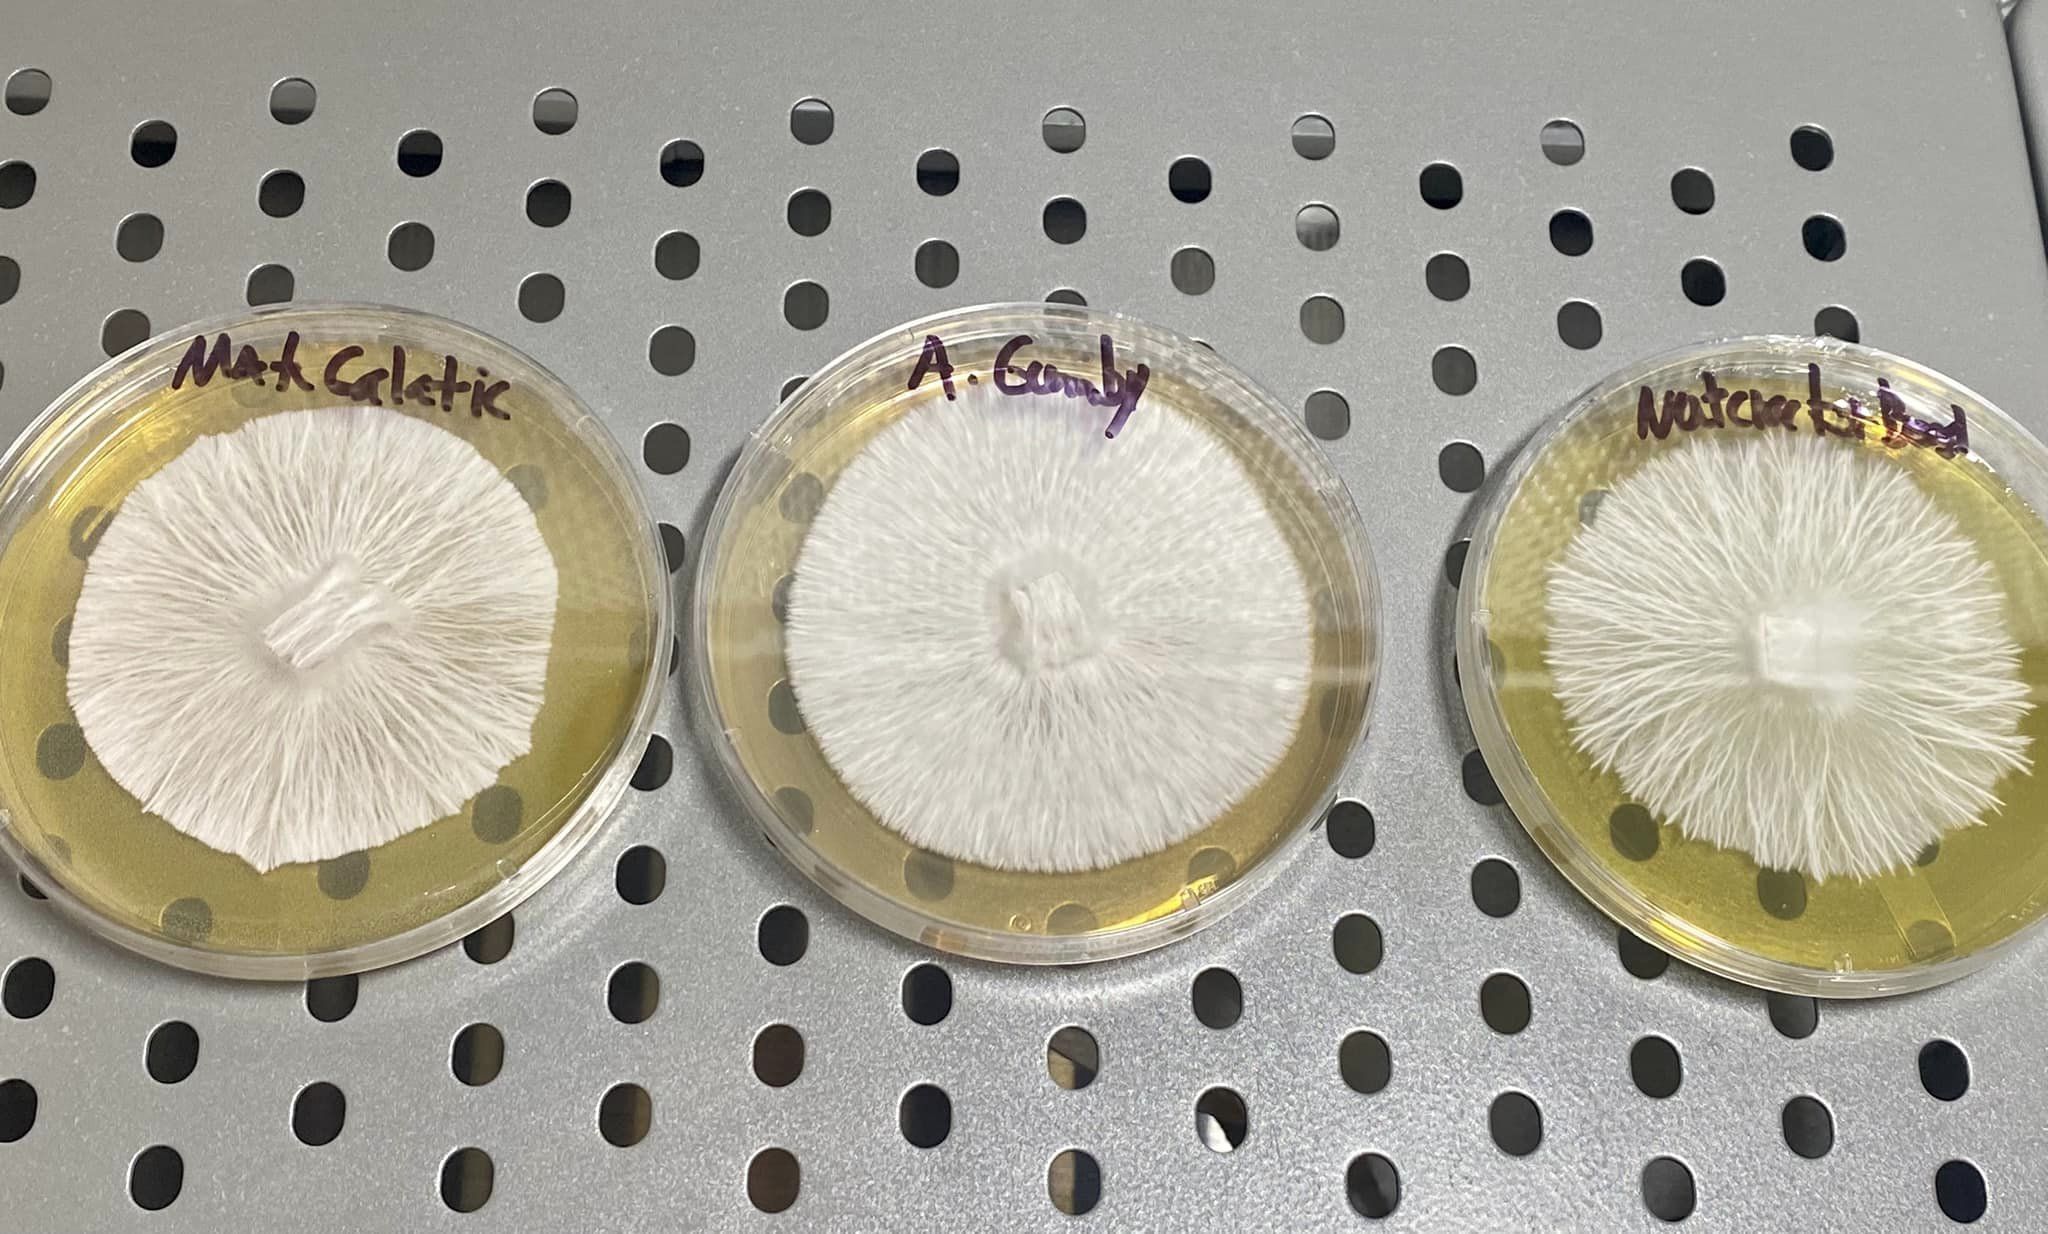
...

PDA TEK
Medio de cultivo para el estudio morfológico de hongos Además, la fórmula es adecuada para la mantención y conservacion de cultivos

PF TEK
Éste método convirtió el cultivo casero de setas en algo factible para aficionados sin grandes conocimientos micológicos, empleando materiales comunes de fácil adquisición.

Sello de esporas
Un sello de esporas es lo que se obtiene al dejar caer las esporas de un fruto del hongo sobre una superficie estéril. Generalmente se suele utilizar papel de aluminio, placas petri o un frasco de vidrio.

Contaminaciones
Un sello de esporas es lo que se obtiene al dejar caer las esporas de un fruto del hongo sobre una superficie estéril. Generalmente se suele utilizar papel de aluminio, placas petri o un frasco de vidrio.
